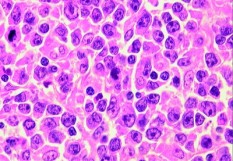

Ces traitements représentent une voie thérapeutique porteuse d’espoir pour lutter contre certaines hémopathies malignes. Il s’agit de thérapies géniques, fabriquées à partir des lymphocytes T du patient qui, une fois modifiés génétiquement et réinjectés, deviennent capables de reconnaitre et détruire spécifiquement les cellules cancéreuses. Pour le moment, deux traitements CAR-T ont reçu, en aout 2018, une autorisation de mise sur le marché (AMM) en Europe : le Kymriah (tisagenlecleucel) de Novartis et le Yescarta (axicabtagene ciloleucel) de Gilead Sciences. Le traitement de Gilead était dispensé aux patients jusqu’à présent grâce à une autorisation temporaire d‘utilisation (ATU) pour le traitement de 3e ligne ou plus du lymphome diffus à grandes cellules B (LDGCB) ou du lymphome médiastinal primitif à grandes cellules B (LMPGCB) réfractaire ou en rechute. Il est constitué de lymphocytes T autologues prélevés par leucaphérèse puis, génétiquement modifiées ex vivo, pour exprimer un récepteur chimérique à l’antigène ciblant la protéine CD19 présente sur les cellules de la lignée B. Les cellules CAR T anti-CD19 ré-injectées se multiplient et s’activent in vivo après leur liaison aux cellules cibles exprimant le CD19 induisant leur apoptose. La Haute autorité de santé (HAS), lui a accordé une amélioration du service médical rendu (ASMR) de niveau III par rapport à la prise en charge actuelle dans cette indication. Les études réalisées montrent, en effet, un taux de réponse objective (TRO) de 83 %, avec 58 % des patients ayant obtenu une réponse complète (RC). Avec un suivi médian de 27,1 mois, la réponse était maintenue chez 39 % des patients. Sept établissements ont pour le moment la capacité... de dispenser ce traitement en France. Au total dans le monde, 1000 patients ont déjà reçu cette thérapie. Mais le laboratoire espère pouvoir en développer l’accès pour améliorer la prise en charge des patients en impasse thérapeutique. Pendant la période de l’ATU, le traitement était mis à disposition à titre gracieux ; depuis janvier 2019, une indemnité était fixée au laboratoire. Le prix de Yescarta était fixé, pendant cette période, à 350 000 euros. "L’accord trouvé sur notre thérapie CAR T consacre l’accès à une révolution thérapeutique et l’espoir considérable que représente ces traitements pour les patients aujourd’hui et demain", a déclaré Michel Joly, président de Gilead Sciences en France. Selon le laboratoire, "environ 400 patients français sont éligibles à ce traitement et le coût de ces traitements représentera moins de 0,5 % du coût du cancer en France". Médecins du monde a introduit récemment une opposition au brevet du Kymriah de Novartis, du fait du prix élevé de ces traitement CAR T, afin d’interpeller le grand public et les pouvoirs publics sur la menace que cela fait peser sur l’accès au soin, considère l’association.
La sélection de la rédaction

Faut-il restreindre les conditions d'accès au secteur 2?
Herve Koskas
Non
Nous restons dans le gre à grè. L information doit etre claire: pas de surprise ; pas de dessous de table; c'est le but du S2 !. ... Lire plus